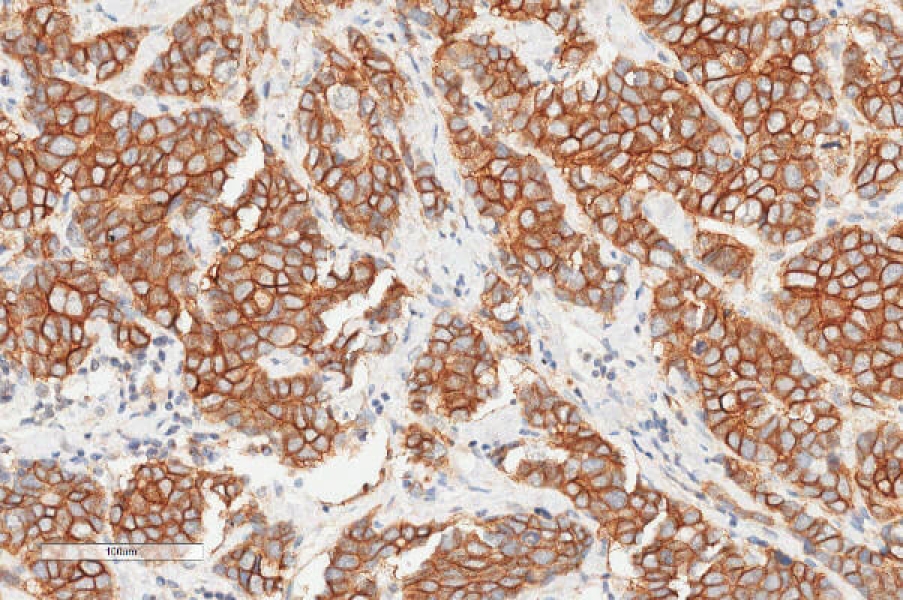
Link to /sites/default/files/styles/slider_desktop/public/images/slide/ihc-staining-her-2.jpg?itok=1_lFfpUs

This facility derives partial funding from the FCCC Cancer Center Support Grant (CCSG) from the National Cancer Institute.
- Autopsy procedures and macroscopic evaluation
- Tissue processing, paraffin embedding and sectioning
- Frozen OCT blocks and cryosectioning
- H&E staining and special staining; serial/spaced sections
- Immunohistochemistry (new antibody assay development)
- Multiplex IHC/IF staining
- Histopathology reports, Histologic scoring and IHC scoring
- Digital microphotography
- Digital whole slide scan
- Machine learning and AI-based image analysis via Visiopharm Software
- Laser Capture Microdissection
Tissue processing/paraffin blocks and sections
Preparation of histological sections from tissues provided by investigators.
Tissue sectioning from frozen blocks
Preparation of OCT frozen block and histological cryosections from tissues provided by investigators.
HE staining and special stain (Trichrome stain, etc.)
H&E and other traditional histological techniques for microscopic evaluation of tissues and cells.
Immunohistochemistry (IHC), since and multiplex IHC staining
Detection of cancer-related proteins in tissue sections. Multiple immunohistochemistry (IHC) assays enable detection of multiple targets in one section.
Single IHC Staining
Available Double IHC panels
Interpretative pathology and histopathology reports
Facility pathologists read slides and report on abnormalities found when requested.
Digital photography
Facility pathologists document microscopic findings when requested
Digital whole slide scan
IHC manual score and digital image analysis
Advanced computer-assisted image analyzers that permit morphometric and densitometric analysis of tissue components and IHC reactions.
Tissue Microarray analysis (morphology and IHC evaluation)
Facility pathologists provide the morphology and IHC evaluation of Tissue microarray slide.
Laser Capture Microdissection
Capable of isolating Normal, Tumor, or Stroma components from either frozen and paraffin sections. Insure the pure cell populations for downstream DNA, RNA and proteomics analysis.